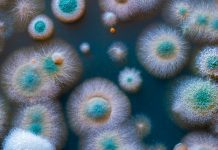

Health-022-August-2022 Related News
Health Europa Quarterly Issue 22
Welcome to Health Europa Quarterly Issue 22, which features fascinating expert insights in the fields of public health, Alzheimer's disease, antimicrobial resistance, women’s health, nutrition,...
Extending the UK’s leadership with an antibiotic subscription model to tackle AMR
Following the UK’s top ranking in the recent AMR Preparedness Index, Michael Hodin and Peter Jackson discuss the country’s novel antibiotic subscription model and...
New tool provides insights into Long COVID syndrome symptoms
With over 200 symptoms associated with long COVID syndrome, we spoke to Dr Sarah Hughes from the University of Birmingham about the significance of...
Why sustainable diets are essential for protecting the public and planetary health
Dr Marco Springmann outlines the urgent need to adopt more sustainable diets to safeguard global food supplies as well as public and planetary health.
What...
Is atrial fibrillation a cause of dementia?
Following new evidence suggesting a link between atrial fibrillation and cognitive decline and dementia, Health Europa Quarterly spoke to Professor Ben Freedman of the...
Broadening the availability of orphan drugs
Ahead of the EU’s revision of the regulatory framework governing orphan drugs, we spoke to the European Medicines Agency about some of the key...
Urgent action needed to support young people’s mental health
Following this year’s European Mental Health Week, Health Europa Quarterly spoke to Mental Health Europe about the importance of supporting young people’s mental Health.
Mental...
Are cannabinoid therapies the future of chronic pain management?
Health Europa Quarterly spoke to Dr Mikael Sodergren who leads the Medical Cannabis Research Group at Imperial College London about his research on novel...
A European health data ecosystem can unlock personalised healthcare
Oliver Bleck discusses the rise of platform ecosystems in healthcare, the value of personalised healthcare and the need for an agile environment to support...
Bite Back 2030: ‘The food system is rigged against us’
The young campaigners of Bite Back 2030 are calling for more to be done to protect children from diet-related ill-health. Here, they tell Health...
Project HOPE: Rebuilding the healthcare system in Ukraine
President and CEO of Project HOPE, Rabih Torbay, shares his experience of being on the ground in Ukraine and the many challenges the healthcare...
Advancing nurses’ expertise on antimicrobial resistance
Ber Oomen, executive director of the European Specialist Nurses Organisation spoke to Health Europa about the organisation’s AMR, vaccination and infection prevention focus group and...
International study identifies new risk genes for Alzheimer’s disease
Professor Jean-Charles Lambert, who spearheaded the most extensive ever genome-wide association study for Alzheimer's disease, outlines how the project has discovered 75 risk genes...
Diversifying care delivery with digital healthcare technology
Badri Wadawadigi discusses how current and emerging digital healthcare technologies are being optimised to improve care delivery and the importance of tailoring solutions to...
Tackling obesity in children
With record numbers of overweight and obesity in children, Health Europa Quarterly discusses the key risk factors and challenges around policy and care delivery...
Food for thought: nutrition as a treatment for mental health conditions
Our diet can have a huge impact on our mental wellbeing, but what potential does nutritional therapy hold for the treatment of mental health...
Six benefits of using CBD oil for anxiety
What are the benefits of CBD oil for anxiety? Dr. Hemp Me outlines everything you need to know about supplementing with CBD oil.
Anxiety disorders...
The urgent care crisis in the UK
Dr Richard Gilpin, Specialist Registrar in Geriatric Medicine and member of the Doctors’ Association UK editorial board, discusses the current challenges facing urgent care...
Removing barriers to create digital healthcare services that work for everyone
Trilly Chatterjee of NHS Digital outlines the benefits of digital healthcare services in improving delivery of care.
For several years preceding the COVID-19 pandemic, and...
How can we optimise emergency preparedness and response?
Preparing for major medical emergencies is integral to protecting populations and optimising collaboration between response teams. Mariano Votta of the Cittadinanzattiva NGO discusses initiatives...